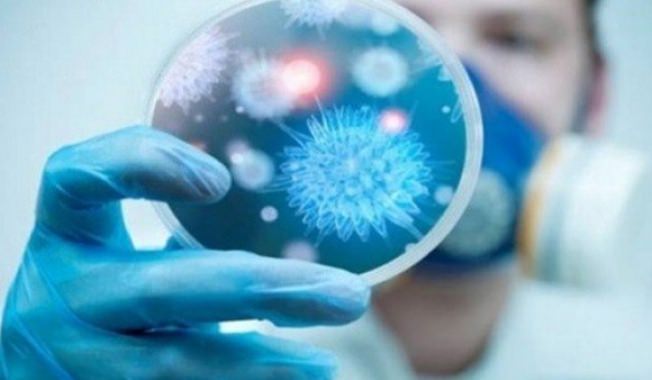
كاميرات الصين تلتقط صوراً لأشخاص ينشرون فايروس كورونا بالاماكن العامة, بالفيديو

اخبار دولية وعالمية
كاميرات الصين تلتقط صوراً لأشخاص ينشرون فايروس كورونا بالاماكن العامة, بالفيديو
29-02-2020, 15:19
الصين تنشر لقطات لكيمرات المراقبة لعدة اشخاص يقومون بنشر الفيروس في الاماكن العامه وهذا ما يؤكد ان من وراء هذه العمليات هي المخابرات الامريكيه والاسرائيله
لا يستبعد ان يكون قد عملوو هذا العمل في ايران لانها العدو الاكبر لامريكا واسرائيل
او انهم الى حتى الان لا زالوا ينشرون الفيروس بهذه الطريقه
الحذر كل الحذر يا شباب من الاماكن العامه
مقابض فتحة السيارات سواء كانت سياراتكم او التكاسي
سلالم الاماكن العامه مثل الجامعات وغيرها
المصاعد ولمس مفاتيحها
